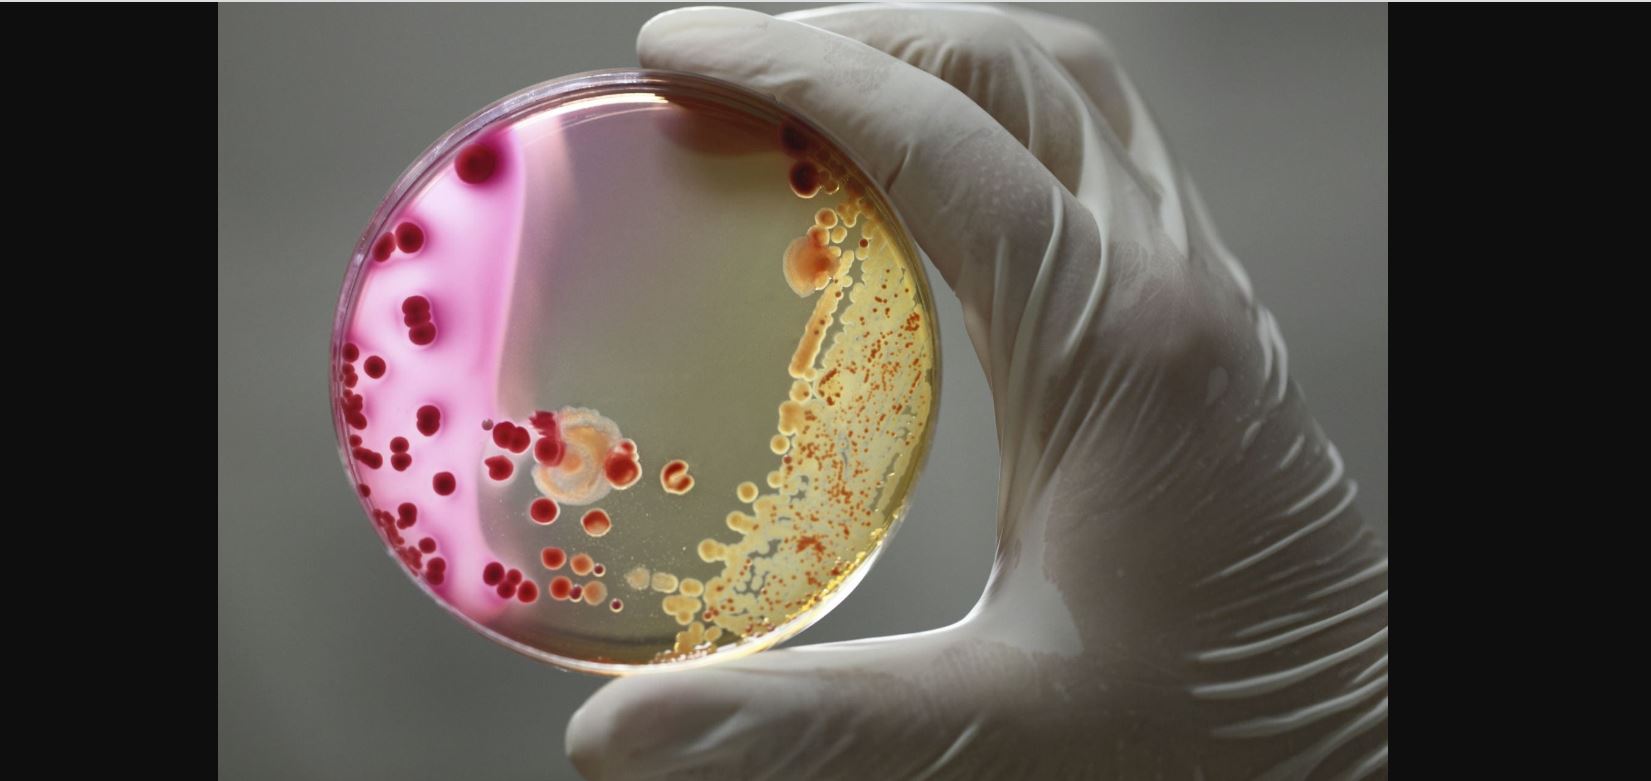

تقرير يوضح الأماكن المفضلة للجراثيم والبكتيريا في المنزل
فكرة بقاء بعض الأماكن في المنزل معقمة وبمنأى عن خطر تواجد البكتيريا تبدو خيالية مها بذلت الاسرة جهودا في ذلك، وبحسب تقرير نشره موقع " دوتشي فيلا الألماني" يبدو أن البكتيريا قد تخفي نفسها وتتواجد في أمكنة بعضها لايخطر على البال منها :
إسفنجة المطبخ
تعد إسفنجة المطبخ من الأشياء الأكثر عرضة لخطر البكتيريا. ويعود سبب ذلك إلى أن إسفنجة المطبخ دائما ما تكون رطبة وتلمس بكثرة بقايا الطعام، ما يجعلها أرضا خصبة للجراثيم. وربما تتسبب الإسفنجة الملوثة في نشر البكتيريا عند عملية استخدامها في المطبخ. لذلك، ينصح دائما باستبدال وتنظيف إسفنجة المطبخ بشكل دوري.
يشار إلى أن دراسة صدرت العام الماضي عن جامعة ديوك الأمريكية أن هيكل إسفنجة المطبخ قد يلعب بدوره دورا في تكاثر البكتيريا ويجعلها مكانا مثاليا للميكروبات، حسب ما أورده موقع مجلة "نيوزويك" الأمريكية.
كأس فرشاة الأسنان
يعد كأس فرشاة الأسنان من الأماكن المفضلة للبكتيريا. وسبب ذلك، هو أن الكثير من الناس نادرا ما يقومون بتنظيف كأس فرشاة الأسنان. وينصح دائما بنتظيف ليس فقط فرشاة الأسنان بل أيضا كأس فرشاة الأسنان لصد البكتيريا، والبقاء بصحة جيدة.
الثلاجة
تواجد البكتيريا في الثلاجة أمر لا يخطر على بال الكثير من الناس، لاسيما وأنها معدة للحفاظ على مختلف الأطعمة الشهية. إلا أن الصورة مغايرة تماما، فالثلاجة واحدة من بين أكثر الأماكن التي تتواجد فيها البكتيريا في المنزل. وتذكر مجلة "فيتال" أن دراسات سابقة توصلت إلى أن هناك عددا أكبر من الجراثيم في الثلاجة مقارنة مع مقعد المرحاض مثلا. لذلك، يجب تنظيف الثلاجة بشكل منتظم ويفضل باستخدام ماء الخل لما له من تأثير مضاد على البكتيريا.
لوح التقطيع
ألواح التقطيع ضرورية للغاية في كل مطبخ. إذ تستعمل لتقطيع الخضار واللحوم والفواكه وغيرها. وما قد لا يعرفه الكثير من الناس أن هذه الألواح مكان خصب للبكتيريا، حيث يمكن أن تتواجد هناك بكل سهولة خاصة في الشقوق الصغيرة. ولا تفرق البكتيريا بين ألواح تقطيع مصنوعة من الخشب أو البلاستيك، فهي تتواجد هناك. ويجب دائما تنظيف هذه الألواح بكثرة، واستخدام ألواح مختلفة للأطعمة المختلفة على غرار لوح خاص باللحوم وآخر بالخضراوات والفواكه.
![]() تابعوا آخر أخبارنا المحلية والرياضية وآخر المستجدات السياسية والإقتصادية عبر Google news
تابعوا آخر أخبارنا المحلية والرياضية وآخر المستجدات السياسية والإقتصادية عبر Google news



